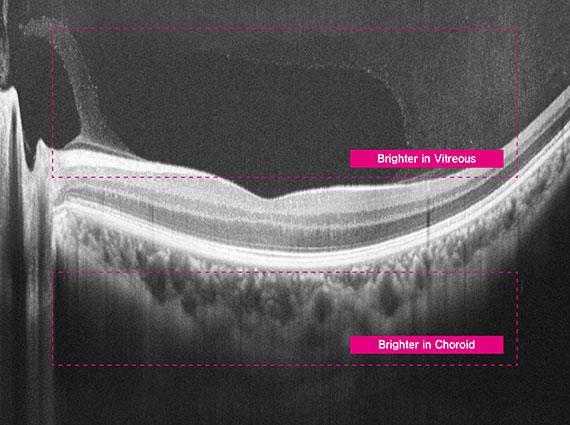
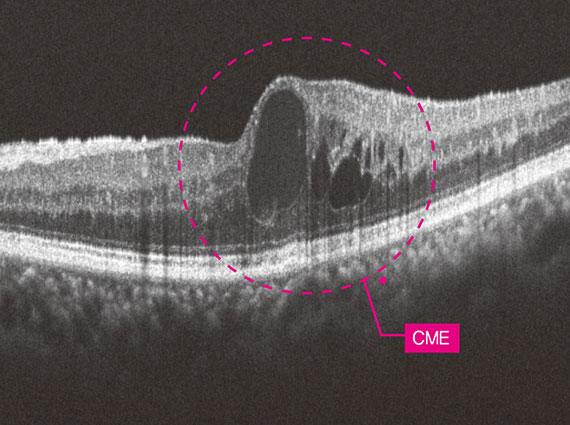

OCTavius
Optical Coherence Tomography
A 5 in 1 ophthalmic diagnostic solution with rapid 80,000 scans per second and true color image quality
- 5 in 1 System : 3D OCT, Fundus Camera, Angiography, Biometry, Topography
- 80,000 A-scan/sec Quick Capture, Clear Answer
- True Color Fundus in One Shot
- Enhanced Angiography Fast OCT-A Imaging, Full Coverage
- Precise and Layered Analysis with Biometry & Topography
- Accurate Analysis
MENU
Explore Details

5 in 1 System : 3D OCT, Fundus Camera, Angiography, Biometry, Topography
OCTavius integrates five essential diagnostic functions—3D OCT, Fundus Camera, Angiography, Biometry, and Topography—into a single device. It offers seamless operation and delivers precise results needed for clinical decision-making. With the 5-in-1 system, enhance your diagnostic accuracy while maximizing workflow efficiency and exam room space.
80,000 A-scan/sec
Quick Capture, Clear Answer
Even with involuntary eye movements or blinking, OCTavius captures stabilized, high-resolution 3D images through ultra-fast scanning at up to 80,000 A-scans per second. This ensures clear, repeat-free imaging—ideal even for beginners. Visualized retinal layers allow clinicians to observe pathological structures such as layer thickness and macular differentiation with greater clarity and confidence.

True Color Fundus in One Shot
With 12-bit color depth and gamma correction, OCTavius captures true color fundus images in a single shot—free from color distortion. It accurately balances contrast across both dark retinal areas and bright optic discs, delivering clear visualization of arteries, veins, and even fine microvasculature. Additionally, it automatically aligns and merges multiple fundus images—up to seven—to generate a widefield panoramic view, enabling intuitive identification of lesion location and extent in a single, comprehensive image.
Enhanced Angiography Fast OCT-A Imaging, Full Coverage
OCTavius offers multiple scan sizes—3×3, 4.5×4.5, 6×6, and 9×9mm²—allowing clinicians to tailor vascular imaging based on lesion location and extent. From localized detail to widefield coverage, it enables efficient and precise visualization of microvasculature in a single, dye-free scan. This reduces diagnostic burden while enhancing workflow efficiency.








Detailed measurement of biometry and topography
OCT Topography enables simultaneous measurement of both anterior and posterior corneal surfaces, delivering detailed, three-dimensional analysis. With 16 types of corneal maps, clinicians can assess corneal thickness, curvature, and elevation changes with precision. Optical Biometry visualizes the full axial structure—from cornea to macula—in high-resolution 2D, providing more detailed data than traditional ultrasound. This supports accurate IOL selection tailored to each patient’s ocular profile.
Accurate Analysis
Through integrated analysis, it's possible to grasp personalized symptoms, diseases, and their progression for each patient at a glance. This includes tracking pathological changes with Progression analysis, comparing pre- and post-treatment states with Compare functionality, analyzing pathological conditions from various perspectives such as key indicators compared to normative data.




Video
Specifications
1. OCT
Principle
Spectral domain OCT, Fundus digital photography
Light source
840 nm
Scan speed
Max. 80,000 A-Scan/sec.
Resolution in tissue
20 um (Lateral), 7 um (z-axis) at index 1.36
Scan Range
X : 6~12 mm, Y : 6~9 mm, Z : 2.34 mm
Display resolution
X : 5.85 um, Y : 23.40 um, Z : 3.05 um
Minimum pupil diameter
2.5 mm
Scan patterns
Macular : Macular Line, Macular Cross, Macular Radial, Macular3D, Macular Raster, Angio (Option)
Disc : Disc Circle, Disc Radial, Disc 3D, Disc Raster, Angio (Option)
Optical power at cornea
≤ 1.3 mW
Acquisition time of 3D image
1.0 sec (Normal Mode, A512xB96)
Depth Accuracy (measuring 1 mm glass)
±3%
2. OCT Angiography – Option (HOCT-1/1F)
Angiography Range
3-9 mm
Angiography Map
Superficial, Deep, Outer, Choroicapilary, Retina, Custom, Enface, Thickness map, Depth coded map
Angiography Analysis
FAZ, Vessel Density
3. Fundus Camera (HOCT-1/1F)
Principle
Non-mydriatic fundus camera
Resolution
60 line pair/mm or more (center), 40 line pair/mm or more (middle), 25 line pair/mm or more (periphery)
Angle of view
45˚
Camera
Built-in 20M pixel, Color
Minimum pupil diameter
4.0 mm (Normal mode), 3.3 mm (Small pupil mode)
Light source
White light, 10 levels
Pixel pitch at fundus
3.69 um (20M pixel Color)
Capture mode
Single, Stereo, Widefield Panorama
4. Common specification
Working distance
33 mm
LCD
12.1 inch, 1280 x 800 pixel, Touch panel color LCD
Dioptric compensation forpatient’s eye
-33D~+33D total, -13D~+13D with no compensation lens, +7D~+33D with plus compensation lens, -33D~-7D with minus compensation lens
Fixation target
LCD (internal), White LED (external)
Fundus illumination light
760 nm
Horizontal movement
70 mm (back and forth), 100 mm (left and right)
Vertical movement
30 mm
Chinrest movement
62 mm (up and down), motorized
Auto tracking
30 mm (up and down), 10 mm (right and left), 10 mm (back and forth)
Power supply
AC 100 - 240 V, 50/60 Hz, 1.6 - 0.7 A
PC
Built in computer
LCD Tilting Angle
70˚
Dimensions / Mass
330 (W) x 542 (D) x 521 (H) mm / 30 kg
5. Anterior segment adapter (optional)
Working distance
15 mm (from anterior segment adapter to ocular globe)
Scan range
6 ~ 9 mm (width), 2.3 mm (depth)
Scan pattern
ACA line, Anterior Radial
Metric
Corneal Layers, Thickness Map, Thickness, Angle
6. Wide Anterior segment adapter (optional)
Working distance
15 mm
Scan range
16 mm (width), 2.3 mm (depth)
Scan pattern
ACA line, Anterior Radial, Full
Metric
Dimension, Angle
7. Biometry (optional)
Metric
AL, CCT, ACD, LT
8. Topography (optional)
Supported Maps
Axial map, Tangential map, Keratoconus Screening
9. HIIS-1 (Optional)
Feature
Web-Based, Multi users can be accessible Progression analysis, Comparison analysis, 3D Analysis
* Specification and design are subject to change without notice.
Related Products
HLM-1
Digital Lensmeter
HLM-7000P
Digital Lensmeter
HLM-9000
Digital Lensmeter
HS Series
Slit Lamp
HNT-1/1P
Non-contact Tonometer
HFC-1
Non-Mydriatic Fundus Camera
HTG-1
Full Corneal Optical Topographer
HRK-1
Auto Ref-Keratometer
HRK-8100A
Auto Ref-Keratometer
HRK-9000A
Auto Ref-Keratometer
HDR-9000
Digital Refractor
HTR-1A
Auto Ref/Keratometer, Non-contact Tono/Pachymeter
HBM-1
Optical Biometer with Full Corneal Topography System
Inquiry
We look forward to your inquiry. please let us know what we can help you with, and we will get back to you as soon as possible.